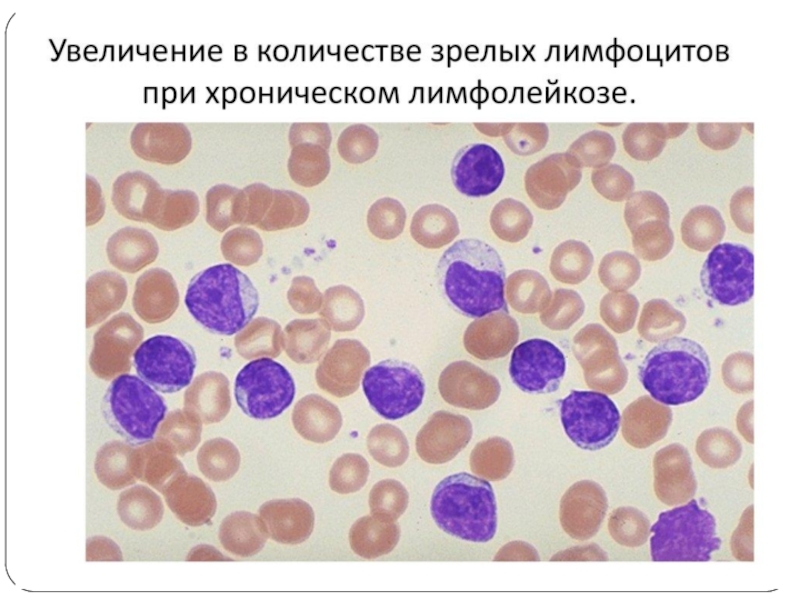
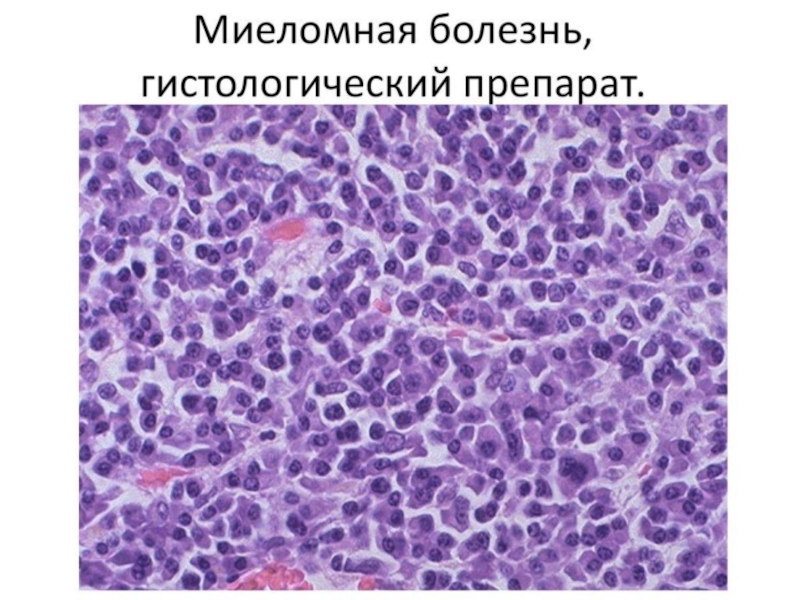
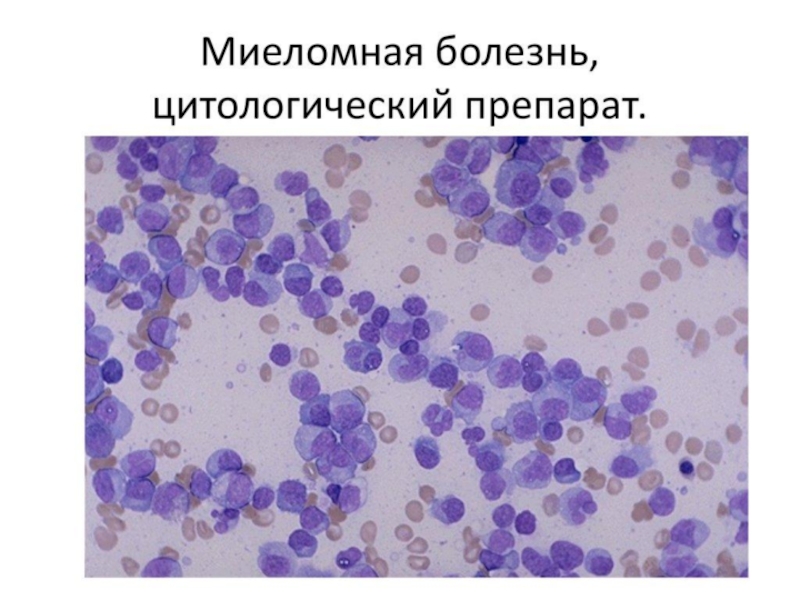

Разделы презентаций
- Разное
- Английский язык
- Астрономия
- Алгебра
- Биология
- География
- Геометрия
- Детские презентации
- Информатика
- История
- Литература
- Математика
- Медицина
- Менеджмент
- Музыка
- МХК
- Немецкий язык
- ОБЖ
- Обществознание
- Окружающий мир
- Педагогика
- Русский язык
- Технология
- Физика
- Философия
- Химия
- Шаблоны, картинки для презентаций
- Экология
- Экономика
- Юриспруденция
Ішкі аурулар кафедрасы СӨЖ
Содержание
- 1. Ішкі аурулар кафедрасы СӨЖ
- 2. Слайд 2
- 3. Опухоли системы кровиЛейкозыЛимфомы
- 4. Слайд 4
- 5. Слайд 5
- 6. Слайд 6
- 7. Слайд 7
- 8. ЛейкозыЭтиологияВирусыИонизирующее излучениеХимические веществаИммунодефицитыГенетическая предрасположенность
- 9. КлассификацияПо клиническому течению:ОстрыеХроническиеПо гистогенезу и дифференцировкеОстрые лейкозы1)Недифференцированный2) Миелобластный3) Лимфобластный4)Монобластный5)Эритробластный6)Мегакариобластный
- 10. КлассификацияХронические лйкозыМиелоцитарного происхожденияХронический миелоидный лейкоз, эритремия, истинная
- 11. КлассификацияПо картине периферической кровиЛейкемические (до 1 млн /мкл)Сублейкемические (15-25 тыс/мкл)Алейкемические (4-10 тыс/мкл)Лейкопенические ( 1-2 тыс/мкл)
- 12. Острые лейкозы
- 13. Красный костный мозг при недифференцированном лейкозе
- 14. Острый промиелобластный лейкоз
- 15. Поражение печени и кожи при острых лейкозах
- 16. Хронические лейкозы
- 17. Слайд 17
- 18. Иммунохимические варианты:G-миеломаА-миеломаD-миеломаЕ-миеломаМиелома Бенс-Джонса
- 19. Слайд 19
- 20. Слайд 20
- 21. Слайд 21
- 22. Слайд 22
- 23. Слайд 23
- 24. Лимфомы. Классификация.НеходжкинскиеЛимфома ХоджкинаПо характеру ростаФолликулярныеДиффузные
- 25. По цитологической характеристикеЛимфоцитарныеПролимфоцитарныеЛимфобластныеПролимфоцитарно-лимфобластныеИммунобластныеПлазмоцитоидныеГистиоцитарныеПо клоновому принципуВ-лимфоцитарныеТ-лимфоцитарныеГистиоцитарныеЛимфомы из натуральных киллеров
- 26. ЭтиологияВирусыОнкогеныАутоиммунные и иммунодефицитные состояния
- 27. Слайд 27
- 28. Слайд 28
- 29. Слайд 29
- 30. Слайд 30
- 31. Слайд 31
- 32. Слайд 32
- 33. Слайд 33
- 34. Слайд 34
- 35. Слайд 35
- 36. Слайд 36
- 37. Скачать презентанцию
Опухоли системы кровиЛейкозыЛимфомы